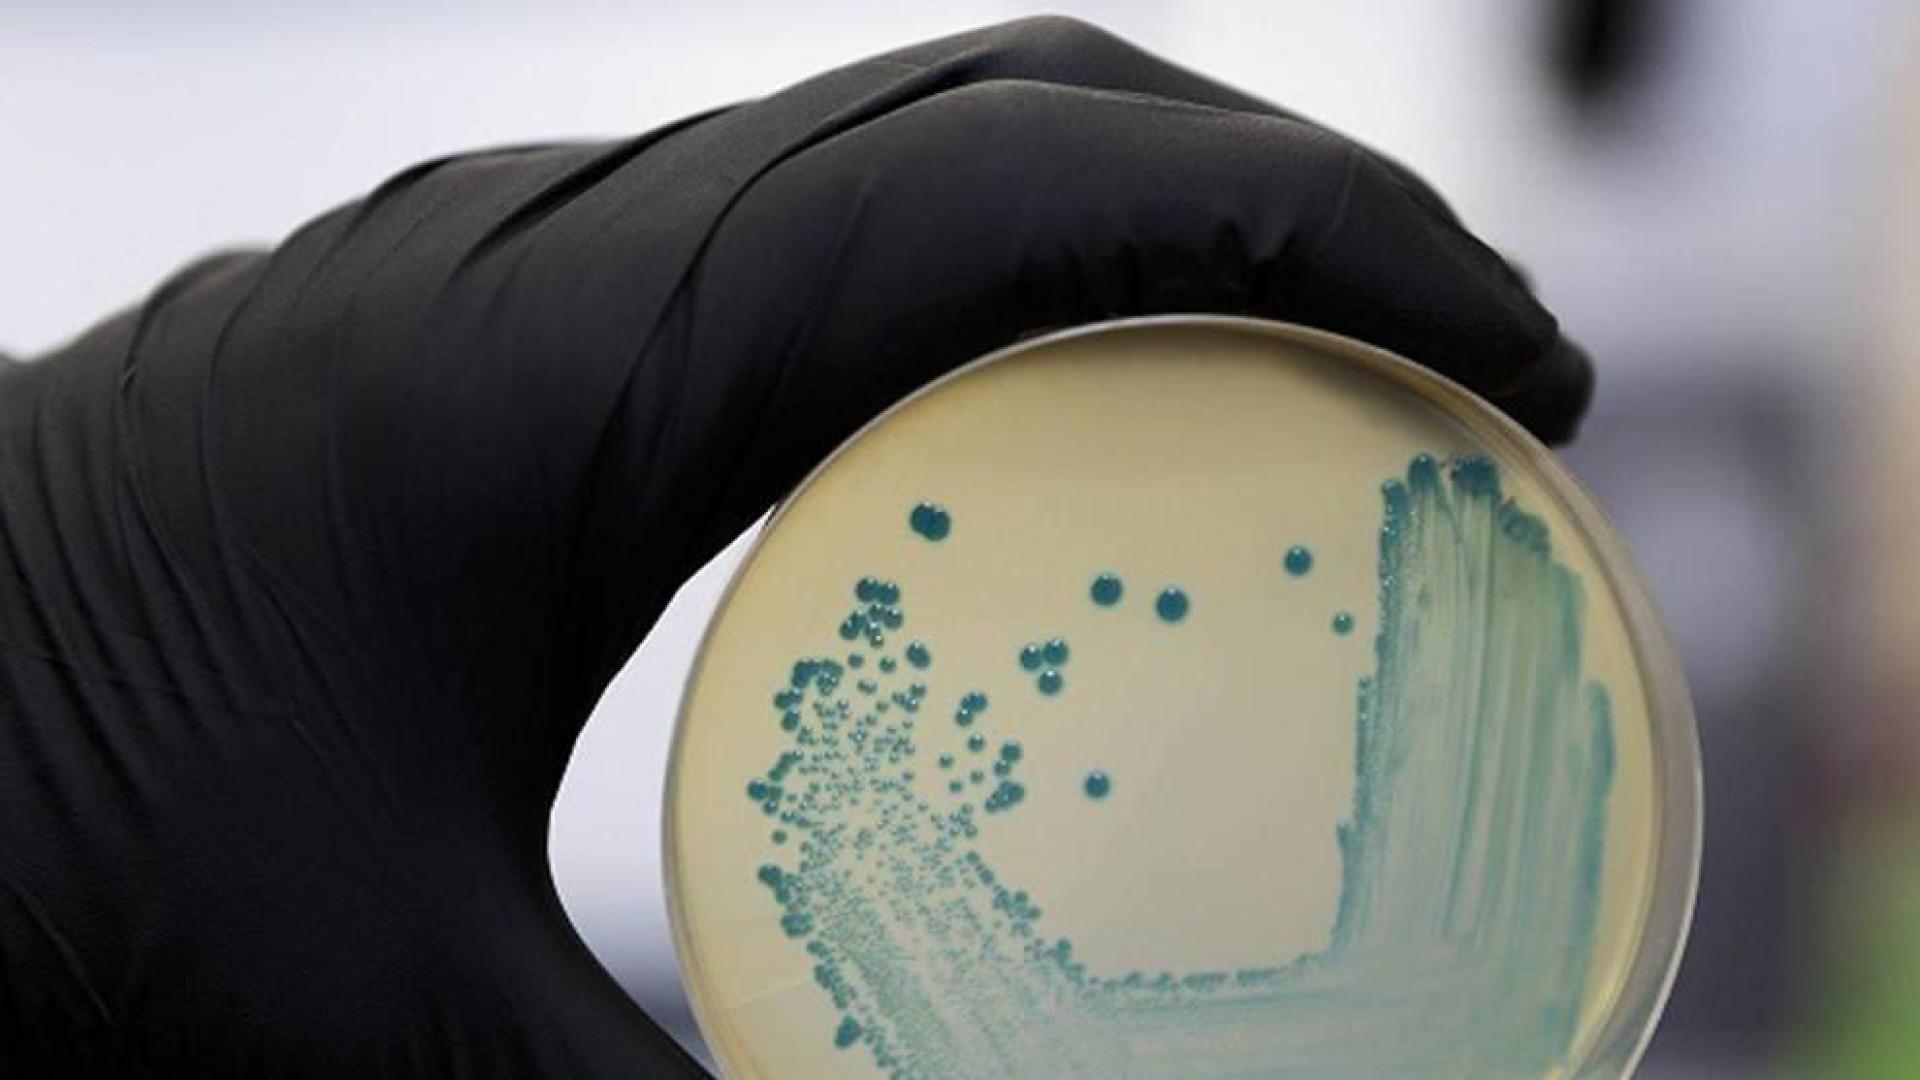
Imagen de un cultivo de la bacteria listeria.

Cada año se detectan de 5 a 10 casos de listeriosis en Navarra
Hasta julio se han declarado dos afectados por esta enfermedad y el año pasado fueron 5

Actualizado el 28/08/2019 a las 07:53
Navarra registra cada año una media de entre 5 y 10 casos de listeriosis, una enfermedad infecciosa de transmisión alimentaria causada por la bacteria listeria. Se trata, fundamentalmente, de casos aislados en personas que suelen pertenecer a grupos...